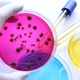

-
Durante los dos primeros milenios de esta civilización naciente , si bien se descubrieron nuevas técnicas de manufactura. Se caracterizo por un cuidadoso pulido de la piedra.La alfarería fue otro de los factores que contribuyeron en el desarrollo.
-
Se supone que el descubrimiento del cobre se hizo cuando alguien se dio cuenta en el fuego de leña, después de las cenizas que se veían una pequeñas piedras azules, las cuales cuando se queman se convierten en cobre.
-
Los primeros metales debieron encontrase en forma de pepitas. Y con seguridad fueron trozos de cobre o de oro ya que estoy soy de los pocos metales que se hayan libres en la naturaleza. El color rojizo del cobre y el tono amarillo del oro debieron de llamar la atención.
-
Se descubrió una variedad de cobre especialmente dura, obtenida al calentar juntos minerales de cobre y de estaño, casi seguro por accidente.
-
La alección del cobre y estaño , se le llamo bronce ya era lo bastante común, como para ser utilizado en la confección de armas y corazas.
-
El químico inglés Stephen Hales da un gran paso al recojer gases sobre el agua.
-
El secreto de la fundición del hierro fue desvelado en el extremo oriental de Asia menor.
-
El escolàstico inglès Robert de chester figura entre los primeros, que tradujeron una obra arabe de alquimia al latìn.
-
Los dorios, antigua tribu griega, equipados con armas de hierro, invadieron la península griega desde el norte y gradualmente fueron venciendo a los pueblos Micénicos.
-
Antigua tribu griega, equipados con armas de hierro, invadieron la península de gracia desde el norte
-
La primera cruzada fue en 1096, los cristianos europeos conquistaron jerusalen en 1099.Durante casi dos siglos consecuentes existio un dominio cristiano en la costa siria, como una pequeña isla en el oceano musulman.
-
Los filisteos, el primer ejercito mas equipado con armamento de hierro, lo que le permitió formar un poderoso imperio.
-
Cuando Citaron a constantinopla, fueron derrotados por el "fuego griego", una mezcla quimica que ardia con gran desprendimiento de calor sin poder apagarse con agua y que desruyo los barcos, de madera de la flota arabe.
-
El mantenimiento y la existencia de la alquimia greco-egipcia estuvo totalmente en manos de lo arabes, rindio sus mejores futuros en los comienzos de su dominaciòn.
-
Invadieron Egipcio y, tras rapidas victorias, ocuparon todo el pais, en los años siguientes persig sufrio el mismo destino.
-
Fué Tales, en meditar correcta y profundamente sobre el significado de los cambios en la naturaleza de la materia.
-
El surtir e inteligente pueblo griego dirigía su atención hacia la naturaleza del universo y las estructuras de la materia que lo componían
-
El razonamiento llevó a Anaximenes de Mileto a la conclusión, de que el aire era el elemento constituyente del universo.
-
Llevaron consigo a persia el pensamiento griego incluyendo muchos libros de alquimia, y alcanzaron en cenit su poder e influencia.
-
El filosofo Heráclito tomó un camino diferente. Para é el fuego presidian todos los cambios.
-
(aproximadamente 582-430 a.c) natural de una isla no pertenece a jo-nía, abandono samon, para trasladarse al sur de Italia, donde se dedico a la enseñanza, dejándolo tras de si un influyente cuerpo de doctrina
-
Demócrito llamó átomo a las partículas que alcanzaron el menor tamaño.
-
Leucipo afirma que cualquier trozo de materia, por muy pequeño que sea, siempre puede dividirse en trozos mas pequeños.
-
Aristóteles fué el filosofo mas influyente de los filosofos griegos, aceptó la doctrina de los cuatro elementos.
-
Epícuro incorporó el atomismo a su linea de pensamiento.
-
Se disgregó después de su muerte, pero los griegos y macadonios mantuvieron el control de grandes áreas de oriente medio.
-
Durante la dominaciòn romana el arte ja Khermeia entro en declive, junto con la decadencia general del conocimiento griego
-
Lucrecio expuso la teoría atomista de Demócrito y Epícuro en un largo poema titulado De rerum natura.
-
El químico escocés Joshep Black hizo una tesis que le mereció una graduación, lo que hizo fué calentar certamente la piedra caliza (carbonato cálcico). Ese carbonato se descompuso, liberando un gas y dejando cal (ácido de calcio) tras de si. El gas liberado pudo recombinarse con el oxido de calcio para formar de nuevo carbonato cálcico.
-
Ya se había licuado el gas amoniaco enfriandolo bajo presion
-
cuando Dalton expuso su nueva versión de la teoría atómica basada en las leyes de las proporciones definidas y de las proporciones múltiples, reconoció su deuda con Democrito manteniendo el termino átomo para las pequeñas partícula que formaban la materia.
-
Berzelius sugirió que las substancias como el aceite de oliva o el azúcar, productos característicos de los organismos, se llamasen orgánicas.
-
El químico francés Michel Chevreul trató jabón con ácido, y aisló lo que ahora se llaman ácidos grasos. mas tarde mostró que cuando las grasas se transforman en jabón, el glicerol se separa de la grasa.
-
El pionero en este campo fue un químico ruso, Gottlieb Sigismund Kirchhoff. Logró convertir almidón (calentándolo con ácido) en un azúcar simple que llamo finalmente glucosa.
-
El anti-proton se resistió a ser detectado durante otro cuarto de siglo. como el anti-proton 1836 veces mas energía para su formación.
-
El trabajo de los físicos Alemanes Julius Robert, Von Mayer, puso en claro que en los vicisitudes sufridas por el calor y otras formas de energía, no se destruye ni se crea energía. Este principio se llamo la ley de conservación de la energía, o principio de la termodinámica.
-
El físico ingles william crookes ideo un tubo con un vació mas perfecto, que permitía estudiar con mayor facilidad el paso de la corriente eléctrica a través del vació.
-
Un físico americano Josiah Willard esta aplicando sistemáticamente las leyes de la termodinámica a las reacciones químicas.
-
Ostwald preparo un resumen de un trabajo de otro autor sobre el calor de combustión alimentos
-
se trabajaron con grandes minerales, tratando de concentrar la radio actividad y de aislar el nuevo elemento, en julio lograron, su nuevo objetivo y llamaron al nuevo elemento, polonio debido al origen.
-
El físico alemán Friedrich Ernst descubrió un gas radioactivo, que posteriormente recibió el nombre de radón.
-
Había buenas razones para preferir la ultima alternativa y suponer que las partículas de lso rayos catodicos eran mucho menores que cualquier átomo. quedo esto definitivamente probado por el físico americano robert milikan, que midió con bastante exactitud con la mínima carga eléctrica que podía transportar una partícula.
-
Rutherford demostró que las partículas alfa podían arrancar protones de los núcleos de nitrógeno, y fusionarse con lo que quedaba.
-
El químico americano william francis, logro demostrar que el oxigeno estaba formado de tres isotopos. la variedad mas abundante que comprendía cerca del 99,8 por 100 del total de átomos, era el oxigeno 16.
-
Los Joliot-curie habían producido el primer caso de radiactividad artificial. se han formado miles de isotopos no existentes en la naturaleza, y todos ellos son radio activos. cada elemento posee uno o mas isotopos radio activos. incluso el hidrógeno ( también llamado tritio) con una vida media de doce años.
A list shows items. A timeline shows sequence.
Use Timetoast to make dates, milestones, and turning points easier to understand in a clear visual format. Timetoast is a timeline maker for work, school, research, and stories.